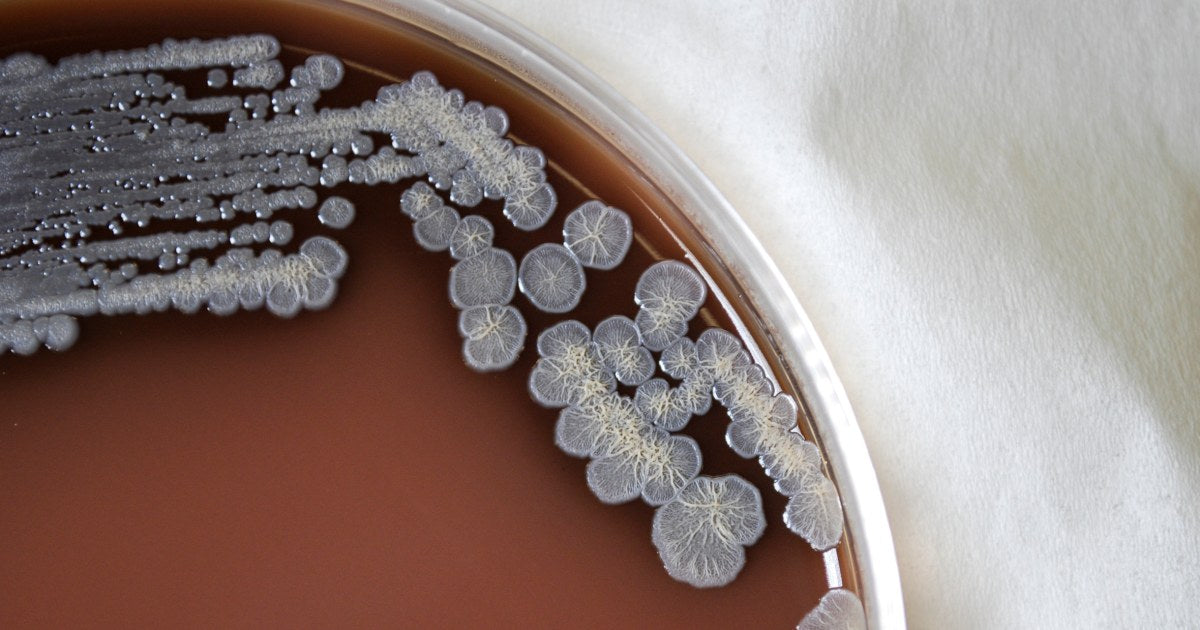
Bacteria that can cause deadly infections found in U.S. soil and water for the first time

Free HK shipping for orders above 500 HKD. Free worldwide shipping for orders above 200 USD.
A potentially deadly type of bacteria previously found only in parts of Southern Asia, Africa or Australia has been detected for the first time in soil and water samples in the United States, the Centers for Disease Control and Prevention said Wednesday.
The bacteria, Burkholderia pseudomallei, can cause an illness called melioidosis that has proven fatal in half of cases worldwide.
About a dozen cases are discovered each year in the U.S., usually among people who had traveled overseas.
On Wednesday, however, the CDC announced the bacteria had been found in soil and water samples along the Gulf Coast of Mississippi, and issued a health alert to physicians nationwide to be on the lookout for symptoms of melioidosis, which can be vague, including cough, fever and chest pain. In more severe cases, the illness can lead to disorientation, pneumonia-like illness and seizures.
"It is unclear how long the bacteria has been in the environment and where else it might be found in the U.S.," the CDC said in a statement.
Dr. Jill Weatherhead, an assistant professor of tropical medicine and infectious diseases at the Baylor College of Medicine in Houston, was not surprised that the bacteria had made their way into this country.
"We live in a subtropical climate here in the U.S. along the Gulf Coast, where it's warm and humid. This is a suitable environment for Burkholderia pseudomallei," she said.
The bacteria have the potential to thrive anywhere along the Gulf Coast, she said, and could potentially become endemic.
The discovery of the bacteria in U.S. soil comes after two people who were not related but lived near each other in Mississippi became sick with melioidosis — one in 2020 and the other in 2022.
According to the CDC's health alert for doctors, both patients were hospitalized with sepsis after developing pneumonia. Both were given antibiotics and recovered.
Samples taken from the soil and puddles near the patients' homes contained the bacteria, confirming its presence in the U.S., the CDC said.
The same bacteria were also found last year in contaminated aromatherapy room spray that sickened four people in Georgia, Kansas, Minnesota and Texas. The cases were unrelated to the current alert, as the spray had been imported from India, where B. pseudomallei are endemic.
Two of those people, including a 5-year-old boy, died. The other two patients were left with lasting physical and mental health problems.
Walmart, which sold the imported product, recalled nearly 4,000 bottles of its "Better Homes & Gardens Lavender & Chamomile Essential Oil Infused Aromatherapy Room Spray with Gemstone."
Although B. pseudomallei have now been found in U.S. soil and water, infectious disease experts say it's unlikely the bacteria will cause widespread harm.
"It takes a significant exposure," either through an open sore or ingestion, to cause illness in people, said Dr. Chris Woods, a professor of medicine with the Duke Global Health Institute.
Usually, he said, that occurs in places where the bacteria have grown and become concentrated.
While melioidosis is treatable with certain intravenous antibiotics, doctors say it can be difficult to make a correct diagnosis in time to help patients.
The CDC said that people living along the Gulf Coast of Mississippi may want to take extra precautions when in contact with soil or muddy water, such as wearing waterproof boots and covering open wounds.
This content was originally published here.
